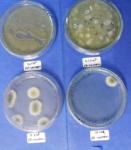
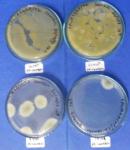
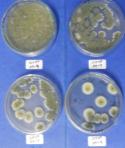
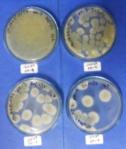
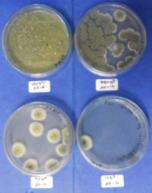
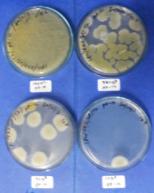
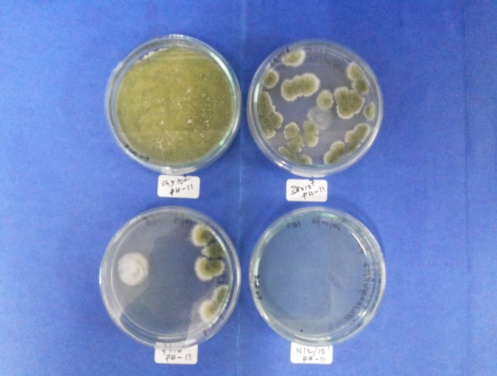
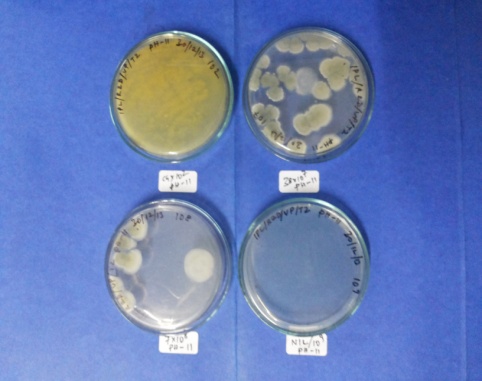
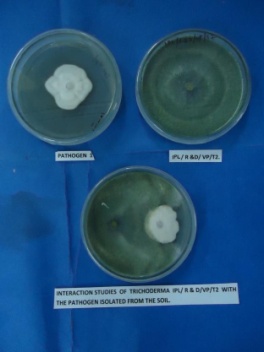
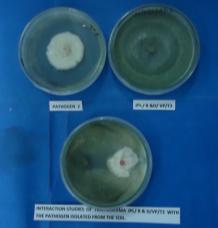
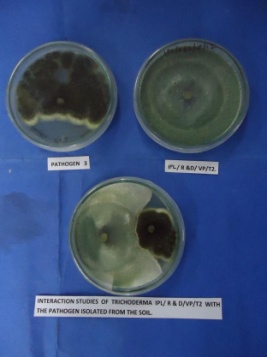
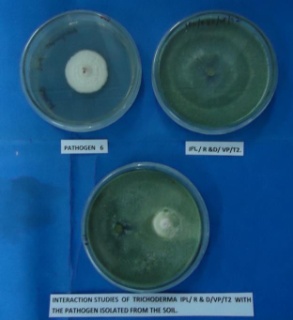
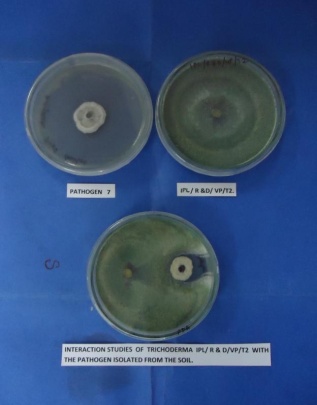
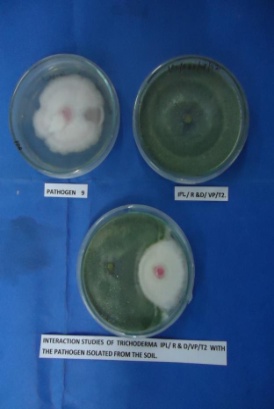
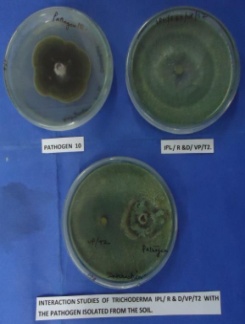
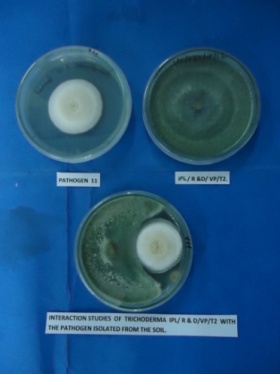
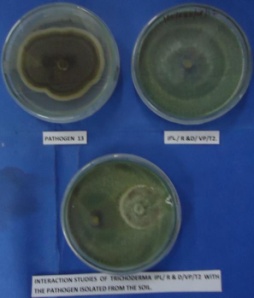
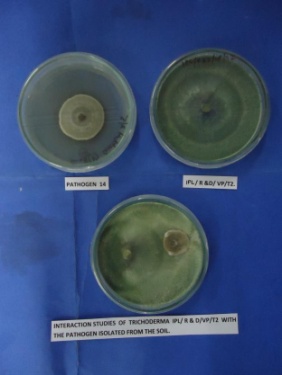

Int J Pharm Pharm Sci, Vol 6, Issue 10, ??-??Original Article
ISOLATION AND SCREENING OF ALKALI TOLERANT TRICHODERMA SPP AS BIOCONTROL AGENT FOR ALKALINE AGRICULTURAL SOIL
T. G. VIMALA KUMARI1*, KAUSIK BASU 1, T. G. NITHYA2, AJIT VARMA 1, AMIT C KHARKWAL1
1Amity Institute of Microbial Technology (AIMT), Amity University Uttar Pradesh, Sector 125, Noida 201303, Uttar Pradesh, India, 2Department of Biotechnology, Faculty of Science and Humanities, SRM University Kattankulathur, India.
Email: vimalasekaranprakash@yahoo.com
Received: 08 Sep 2014 Revised and Accepted: 05 Oct 2014
ABSTRACT
Objective: The main aim of the study was to screen twenty isolates of Trichoderma spp isolated from high alkaline agricultural soil and non agricultural soil and to test them invitro for their pH levels tolerance and biomass production.
Methods: All the twenty Trichoderma spp isolates were assessed for growth and biomass yield at different alkaline pH 9, 10, 11 on nutrient medium PCA and PCB. The growth were measured in terms of mycelial weight (cell biomass) and sporulation. The most tolerant isolates were further studied for their biocontrol activity against phytopathogen isolated from same location.
Results: Significant variations in the growth of the isolates were recorded with increasing pH. Different isolates of same species also varies in their growth and biomass yield at pH 7, 9, 10, and 11. The isolates were screened for highest growth at pH 11 in terms of biomass yield. 12 isolates showed prominent biomass yield at pH 10.0, but only 5 isolates were able to grow prominently at pH 11
Conclusion: The study concluded that Trichoderma spp isolated from alkali soil with a high pH of more than 11 was only able to grow under high pH range of 9, 10, 11 and also exhibited maximum antagnostic activity for the pathogens studied.
Keywords: Trichoderma spp, Alkaline pH, Tolerance, Biomass, Biocontrol.
INTRODUCTION
Biological control of a plant disease has always been thought to be the best remedial measure for disease management. It is an eco-friendly strategy of disease control and if the organism is self perpetuating, its repetitive applications are not required, thus reducing the cost of raising crops considerably. Trichoderma spp strains are of great importance as bio control agents, and should have better stress tolerance levels than the plant pathogens against which they are going to be applied for biological control under field condition [1]. Trichoderma spp is a genus of fungi that is present in all soils, where they are the most prevalent culturable fungi. Many species in this genus can be characterized as opportunistic avirulent plant symbionts[2]. Trichoderma spp have narrow and flexuous conidiophores and branches, with branches and phialides crowded, frequently paired, and seldom with more than three elements in a whorl[3].
The abiotic factors deteriorate the antagonistic properties of Trichoderma spp, against the phytopathogenic fungi [4]. Besides the effect of temperature, heavy metals, water relations, even the pesticides and pH have high influence on growth of phytopathogenic fungi as well as bio control agents. As in all microorganisms even in Trichoderma spp, the external factors modify its morphological characteristics as well as physiological functions [5].
Among these factors, pH is probably the most important environmental parameter affecting the mycoparasitic activities of Trichoderma spp strains [6]. A specific value of pH is required to note the maximum growth where these biocontrol agents can be multiplied and pathogen can be controlled. The studies on the variation of pH by different workers revealed that Trichoderma spp isolates showed optimum growth and sporulation rate at different pH values ranging from 2 to 7 [7].
Biocontrol agents need to be applied to rhizosphere for control of pathogen and enhancing plant growth. Studies suggested that these BCA failed to perform in soil with high alkaline pH. There is a serious problem in initial establishment of these Trichoderma spp isolates when applied in alkaline soil and is a notable problem emerging at a very high rate in present agricultural scenario.
The basic aim was to study indigenous bio control agent for sustainability in high alkaline pH. The present study has been initiated in consideration of developing a novel Trichoderma spp bioinoculants for application in alkaline soil for disease control. The alkali tolerant Trichoderma spp strain will imparts value to modern agriculture.
MATERIALS AND METHODS
Collection and isolation of the Fungus
The experimental material consisted of twenty isolates of Trichoderma spp, out of which 15 strains were isolated from agricultural soil sample collected from two district of Haryana and Gujarat-India and other 5 isolates from non agricultural soil. All the isolates were identified up to species level on the basis of phenotypic and morphological characteristics like colony colour and growth size and shape and branching of conidiophores, patterns and distribution of phialides and its shapes and conidia. The cultures were identified using the available literature [8,9,10, 11, 12].
Effect of pH on growth of Trichoderma spp isolates
Twenty Trichoderma spp isolates were assessed for growth and biomass yield at different alkaline pH 9, 10, 11 on nutrient medium PCA and PCB. The pH was adjusted accordingly. All the treatments were carried out in triplicates. The growth were measured in terms of mycelial weight (cell biomass) and sporulation. The data obtained were subjected to analysis of variance (ANNOVA). Mycelia biomass was considered as the most important determinants and significance of variance is presented in terms of 5% LOS.
Evaluation of Biocontrol properties
Fourteen phytopathogen were isolated from the same location and are known to cause minor or major disease symptoms in a range of plant species. Dual cultures were performed for determination of diffusible metabolites by Trichoderma spp isolate IPL/R &D/ VP/T2 and isolated phytopathogenic test fungus were grown on PDA plates. 5 mm disc of both the fungi (Trichoderma spp. and phytopathogenic test fungus) were placed on PDA plate about 2.0 – 2.5 cm away from each other. The plates were incubated at 25oC for one week. Inhibition of the pathogenic fungal growth was measured. Control was taken without Trichoderma spp in the bottom plate. Observation was recorded after one week and percent inhibition was calculated. All the experiments were conducted in three replications.
RESULTS
Twenty isolates were obtained from the soil sample collected from two different states of Haryana and Gujarat -India and that involved both agricultural and non agricultural soil. The isolates were identified using various morphological keys available. The isolated Trichoderma spp species were differentiated on the basis of conidiophore and conidium morphology.
Isolation of Trichoderma spp isolates
A total of twenty isolates were screened and out of these, 15 isolates were from agricultural soil and 5 isolates were from non agricultural soil. The agricultural soil consists of varied crops like paddy, ground nut, cucumber, onion and so many.
The non agricultural soils were from areas adjacent to land with alkaline pH. The Trichoderma spp isolated from agricultural land are Trichoderma sppviride, Trichoderma sppharzianum, Trichoderma sppasperellum, Trichoderma sppvirens and Trichoderma spplongibrachiatum. Trichoderma spp obtained from non agricultural soils are Trichoderma sppvirens, Trichoderma sppharzianum, Trichoderma sppkoningii.
Effect of pH on growth of Trichoderma spp isolates
All the isolates were subjected to invitro study for alkali tolerance at pH 9,10,11,12 with pH 7 as control. Only five isolates showed a positive growth at pH 11.0.
Statistical Analysis
The data was subjected to analysis of variance (ANOVA) Table3:ANNOVA (Analysis of Variance) and significance of variance was presented at 5% level using IRRISTAT windows ver. 4.1.
Table 1: Isolated Trichoderma spp spp. from agricultural and non-agricultural soils
| S. No. | Isolate No. | Organism |
| 01 | IPL/VP/01 | Trichoderma sppvirens |
| 02 | IPL/VP/02 | Trichoderma sppviride |
| 03 | IPL/VP/03 | Trichoderma sppvirens |
| 04 | IPL/VP/04 | Trichoderma harzianum |
| 05 | IPL/VP/05 | Trichoderma sppviride |
| 06 | IPL/VP/06 | Trichoderma harzianum |
| 07 | IPL/VP/07 | Trichoderma sppasperellum |
| 08 | IPL/VP/08 | Trichoderma sppkoningii |
| 09 | IPL/VP/09 | Trichoderma sppasperellum |
| 10 | IPL/VP/10 | Trichoderma sppkoningii |
| 11 | IPL/VP/11 | Trichoderma sppharzianum, |
| 12 | IPL/VP/12 | Trichoderma sppkoningii. |
| 13 | IPL/VP/13 | Trichoderma sppvirens |
| 14 | IPL/VP/14 | Trichoderma spplongibrachiatum |
| 15 | IPL/VP/15 | Trichoderma sppvirens |
| 16 | IPL/VP/16 | Trichoderma viride |
| 17 | IPL/VP/17 | Trichoderma sppvirens |
| 18 | IPL/VP/18 | Trichoderma harzianum |
| 19 | IPL/VP/19 | Trichoderma harzianum |
| 20 | IPL/VP/20 | Trichoderma harzianum |
Table 2: Effect of pH 7, 9, 10,11, 12 on mycelia biomass (g) of Twenty Trichoderma spp isolates
S. No. |
Isolate No. |
pH 7 |
pH 9.0 |
pH 10.0 |
pH 11.0 |
||||||||||||
3rd day |
5th day |
7th day |
10th day |
3rd day |
5th day |
7th day |
10th day |
3rd day |
5th day |
7th day |
10th day |
3rd day |
5th day |
7th day |
10th day |
||
1 |
IPL/VP/01 |
0.7056 |
0.857 |
1.234 |
1.334 |
0.654 |
0.789 |
1.123 |
1.456 |
0.234 |
0.342 |
0.987 |
0.987 |
0.214 |
0.242 |
0.387 |
0.387 |
2 |
IPL/VP/02 |
0.9087 |
1.023 |
1.354 |
1.456 |
0.986 |
1.345 |
1.987 |
2.435 |
0.987 |
1.234 |
1.987 |
2.426 |
0.876 |
1.209 |
1.876 |
2.123 |
3 |
IPL/VP/03 |
0.876 |
0.945 |
1.357 |
1.396 |
0.834 |
0.945 |
1.342 |
1.301 |
0.345 |
0.345 |
0.879 |
0.873 |
0.112 |
0.213 |
0.479 |
0.579 |
4 |
IPL/VP/04 |
0.973 |
1.123 |
1.456 |
1.582 |
0.832 |
1.234 |
1.432 |
1.578 |
0.832 |
1.567 |
1.789 |
1.589 |
0.745 |
1.456 |
1.678 |
1.567 |
5 |
IPL/VP/05 |
0.543 |
0.786 |
0.932 |
1.153 |
0.456 |
0.687 |
0.823 |
1.023 |
0.234 |
0.345 |
0.945 |
1.008 |
0.132 |
0.123 |
0.564 |
0.987 |
6 |
IPL/VP/06 |
0.721 |
0.834 |
1.123 |
1.375 |
0.562 |
0.748 |
1.345 |
1.456 |
0.234 |
0.345 |
0.346 |
0.456 |
0.112 |
0.223 |
0.345 |
0.321 |
7 |
IPL/VP/07 |
0.675 |
0.723 |
0.983 |
0.985 |
0.543 |
0.653 |
0.897 |
0.927 |
0.321 |
0.345 |
0.876 |
0.867 |
0.223 |
0.245 |
0.576 |
0.687 |
8 |
IPL/VP/08 |
0.675 |
0.776 |
0.887 |
1.136 |
0.576 |
0.625 |
0.778 |
1.234 |
0.231 |
0.321 |
0.567 |
0.675 |
0.234 |
0.268 |
0.456 |
0.458 |
9 |
IPL/VP/09 |
0.765 |
0.908 |
1.123 |
1.235 |
0.723 |
0.823 |
1.205 |
1.298 |
0.823 |
0.856 |
1.605 |
1.698 |
0.786 |
0.869 |
1.505 |
1.678 |
10 |
IPL/VP/10 |
0.678 |
0.734 |
1.345 |
1.456 |
0.689 |
0.654 |
1.234 |
1.345 |
0.389 |
0.354 |
0.734 |
0.745 |
0.234 |
0.243 |
0.654 |
0.654 |
11 |
IPL/VP/11 |
0.556 |
0.886 |
1.586 |
1.589 |
0.435 |
0.713 |
1.432 |
1.123 |
0.224 |
0.223 |
0.334 |
0.567 |
0.112 |
0.119 |
0.245 |
0.345 |
12 |
IPL/VP/12 |
0.434 |
0.678 |
1.457 |
1.435 |
0.334 |
0.546 |
1.231 |
1.267 |
0.233 |
0.345 |
0.879 |
0.978 |
0.345 |
0.378 |
0.678 |
0.789 |
13 |
IPL/VP/13 |
0.786 |
0.978 |
1.345 |
1.457 |
0.345 |
0.567 |
1.210 |
1.100 |
0.145 |
0.456 |
0.710 |
0.900 |
0.104 |
0.234 |
0.564 |
0.700 |
14 |
IPL/VP/14 |
0.879 |
0.978 |
1.732 |
1.832 |
0.789 |
0.856 |
1.508 |
1.556 |
0.389 |
0.467 |
0.908 |
0.956 |
0.334 |
0.412 |
0.907 |
0.934 |
15 |
IPL/VP/15 |
0.765 |
0.9872 |
1.879 |
2.0321 |
0.556 |
0.872 |
1.259 |
1.523 |
0.456 |
0.572 |
1.005 |
1.023 |
0.123 |
0.145 |
0.605 |
0.403 |
16 |
IPL/VP/16 |
0.897 |
0.975 |
1.345 |
1.578 |
0.712 |
0.876 |
1.678 |
1.789 |
0.612 |
0.976 |
1.378 |
1.889 |
0.512 |
0.776 |
1.878 |
1.889 |
17 |
IPL/VP/17 |
0.432 |
0.6578 |
1.472 |
1.541 |
0.034 |
0.056 |
0.167 |
0.310 |
0.00 |
0.00 |
0.00 |
0.00 |
0.00 |
0.00 |
0.00 |
0.002 |
18 |
IPL/VP/18 |
0.669 |
0.789 |
0.856 |
0.893 |
0.567 |
0.589 |
0.786 |
0.987 |
0.267 |
0.489 |
0.786 |
0.887 |
0.112 |
0.438 |
0.656 |
0.778 |
19 |
IPL/VP/19 |
0.632 |
0.789 |
0.993 |
1.456 |
0.546 |
0.754 |
0.853 |
1.345 |
0.446 |
0.654 |
0.953 |
1.001 |
0.245 |
0.546 |
0.753 |
0.998 |
20 |
IPL/VP/20 |
0.856 |
0.9231 |
1.567 |
1.5890 |
0.856 |
0.765 |
1.456 |
1.345 |
0.231 |
0.564 |
1.045 |
1.231 |
0.112 |
0.345 |
1.123 |
1.200 |
A significant variation in biomass production was recorded among all isolates of Trichoderma spp species as well as different isolates of same species at all test pH values of 7, 9, 10 and 11 [Table 1]. Maximum number of isolates showed high biomass production at pH 7.00 followed by 9.00 minimum at pH 10.00only 5 isolates shows prominent growth at pH 11.00. The biomass production after 10 days i. e., at the end of the experiment ranged from 0.00 to 2.132 g in all treatments. With increasing incubation maximum isolates showed a significant increase in biomass at all pH levels 7 – 9,but there was no significant increase in biomass at pH 10 and 11 with time. The biomass production of T. viride(IPL/VP/02, IPL/VP/16) was significantly higher than any other isolate at all pH levels 11 whereas T. harzianum(IPL/VP/04, IPL/VP/20); T. asperellum (IPL/VP/09) showed moderate biomass production. Minimum or no growth at pH 9, 10 was observed with T. virens (IPL/VP/17).
Evaluation of biocontrol properties
Statistical significance of antagonistic effect of isolated Trichoderma sppvirideIPL/VP/02 was tested by‘t’ test (P = 0.05), against 14 isolated phyto pathogen and were expressed as mean ± SD of three experiments, and were subjected for analysis of variance. The dual culture study reveals that there is an antagonistic effect of the alkali tolerant Trichoderma sppviride IPL/VP/02, though considerable variation in biocontrol properties with different pathogen.
DISCUSSION
A significant variation in the biomass of all the Trichoderma spp isolates was observed at different pH levels. The Trichoderma spp isolates from both agricultural soils and non agricultural soil showed their preference of pH 7 for optimal growth. Of all species, the maximum biomass was obtained for strains of T. Viride isolated from agricultural soil and also it was noticed that it utilized nutrients better than any other species at varied pH levels. T. Viride isolates also showed most inhibitory effect on the growth of phytopathogen isolated. Four other strains including strains of T. harzianum and T. asperellum shows prominent mycelia growth at pH level 10-11.
Table 3: Analysis of Data and significant variation
| Sources of variation | Sum of Squares (SS) | Degree of Freedom (d. f.) | Mean sum of squares(MSS) | Fcalculated |
| Between Groups | 35.93 | 15 | 2.396 | 17.55 |
| Within Groups | 40.81 | 299 | 0.1365 | |
| Total | 76.74 | 314 |
| pH 7.0 Control | pH 9.00 |
|
|
| Front view | Reverse view |
|
|
| Front view | Reverse view |
| pH 10.00 | pH 11.00 |
|
|
| Front view | Reverse view |
|
|
| Front view | Reverse view |
Fig. 1: Colony of Trichoderma spp isolates IPL/R&D/VP/T2, grown in different alkaline pH 7, 9, 10, 11.
Table 4: Percent inhibition of isolated phytopathogen by Trichoderma sppvirideIPL/VP/02
| S. No. | Pathogen | % inhibition in radial growth |
| 01 | Pathogen 1 | 50 ± 0.651 |
| 02 | Pathogen 2 | 33.8 ± 1.21 |
| 03 | Pathogen 3 | 64.4 ± 1.345 |
| 04 | Pathogen 4 | 63.8 ± 0.987 |
| 05 | Pathogen 5 | 38.2 ± 2.25 |
| 06 | Pathogen 6 | 45.5 ± 1.36 |
| 07 | Pathogen 7 | 23 ± 1.121 |
| 08 | Pathogen 8 | 70.5 ± 1.201 |
| 09 | Pathogen 9 | 44.2 ± 2.024 |
| 10 | Pathogen 10 | 50 ± 1.354 |
| 11 | Pathogen 11 | 35 ± 2.602 |
| 12 | Pathogen 12 | 75.5 ± 2.121 |
| 13 | Pathogen 13 | 60 ± 0.982 |
| 14 | Pathogen 14 | 59 ± 3.121 |
| Values are mean of three replicates + SD | ||
|
|
|
 |
|
|
|
|
|
|
|
Fig. 2: (1-14): Interaction of Isolated 14 pathogens with Trichoderma spp isolates IPL/R &D/ VP/T2.
But there is a considerable difference in the sporulation among the isolates. Only one T. viride isolates from agricultural soil sporulate with count as high as 2×108 was recorded. Some of the isolates showed biomass production at alkaline pH 9.00-11.00 but the sporulation was extremely low or no sporulation. Isolates from non agricultural soils preferred to grow at pH 7.0 – 10. This clearly indicated that the isolates obtained from agricultural soil have adapted themselves to different pH levels as the cultivation practices are known to affect the pH levels of agricultural soils which are reported to be alkaline [13]. It is different with the soils of non agricultural where there is no human intervention on the change of H+ion concentration of soils. pH suitable for the invitro growth of the fungi was correlated with the pH of non agricultural forestsoil from where these fungi occur[14].
The present study also justify clearly that the isolates source plays an important role. The adaptation of Trichoderma spp isolates with varied pH clearly indicates that isolates from intense agricultural soils are tolerant to varied pH conditions. In contrast, isolates obtained from non- agricultural soils where there is no intervention of agricultural practices are not tolerant to varied pH levels. Hence, the present study recommend the use of these isolates as biocontrol agent (BCA) for obtaining better results in plant disease control. The isolate were tested for its biocontrol ability with 14 isolated phytopathogen and have shown significant results
CONCLUSION
The isolation source of Trichoderma spp isolates has an effect on the biomass production at different pH levels. The isolates from cultivated soils are more adaptive to the tested pH ranges than the isolates from virgin soils. Hence, the Trichoderma isolates isolated from high pH soils were able to grow and tolerate high pH and exhibited maximum antagonistic activity against the pathogens isolated from the alkaline soils. Any ideal Biocontrol Agent has to survive and perform under stress conditions. Soil stress like high pH plays a major inhibitory role in preventing the most virulent culture to multiply and perform its activities. Hence stress tolerant Trichoderma spp especially high pH tolerant Trichoderma spp is required for the crop cultivation under alkaline soil conditions. This study hereby concludes that stress tolerant Trichoderma spp are present under naturally problematic soils and can be isolated successfully and used as biocontrol agent for those problematic soils.
CONFLICT OF INTERESTS
Declared None
REFERENCES
- L Kredics, L Manczinger, Z Antal, Z Penzes, K Szekeres, F Kevel, et al. In vitro water activity and pH dependence of mycelial growth and extracellular enzyme activities of Trichoderma spp strains with biocontrol potential. J Appied Microbiol 2004;96:491-8.
- Harman GE, Howell CR, Viterbo A, Chet I, Lorito M. "Trichoderma species—opportunistic avirulent plant symbionts". Nat Rev Microbiol 2004;2(1):43–56.
- John. Bissett-A revision of the genus Trichoderma II. Infrageneric classification. Canadian J Bot 1991;69(11):2357-72.
- J Dlużniewska. Reaction of fungi of Trichoderma genus to selected abiotic factors. Electronic J Agricultural University 2003;6:04.
- Sarojini C Koll. Growth response of Trichoderma isolates against varying pH levels. Int J Environ Biol; 2012.
- L. Kredics. Influence of environmental parameters on Trichoderma spp strains with biocontrol potential Trichoderma spp Strains with Biocontrol Potential. Food Technol Biotechnol 2003;41(1):37–42.
- S Bandyopadhyay, S Jash, S Dutta. Effect of different pH and temperature levels on growth and sporulation of Trichoderma spp. Environ Ecol 2003;21:770-3.
- J Bisset. A revision of the genus Trichoderma II. Infragernic classification, Canadian. J Bot 1991a ;69:2357-72.
- J Bisset. A revision of the genus Trichoderma III. Section Pachybasium, Canadian. J Bot 1991b ;69:2373-417.
- J Bisset. A revision of the genus Trichoderma III. Additional notes on section Longibrachiatum, Canadian. J Bot 1991c;69:2418-20.
- Nagamani IK Kunwar C. Manoharachary, Handbook of soil fungi, IK. International Private Limited: New Delhi; 2006. p. 409-25.
- GJ Samuels, O Petrini, K Kuhls, E Lieckfeldt, CP Kubicek. The Hypocrea schweinitzii complex and Trichoderma sect. Longibrachiatum, Studies Mycol 1998;41:1-54.
- Sarojini C Koll. Growth response of Trichoderma isolates against varying pH levels. Int J Environ Biol; 2012.
- T Yamanaka. The effect of pH on the growth of saprophytic and ectomycorrhizal ammonia fungi in vitro. Mycol 2003;95:584-9.